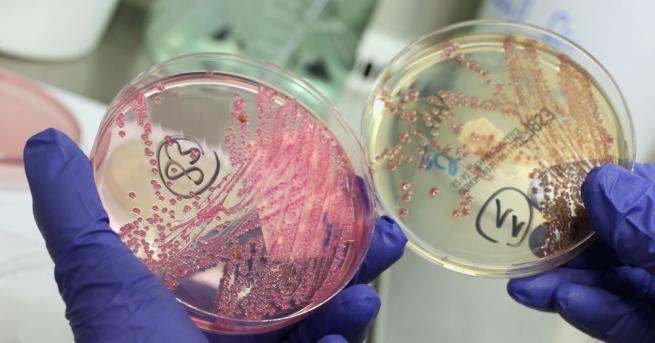
Учени откриха микроби живеещи при 89 градуса Целзий в силно

... или земетресение. Ако беше ударил този район, толкова много хора щяха да загинаха.“ „Самолетът беше наистина близо до нашата къща. Едно от крилата изряза дърво.
Живеещи При - Новини
ул Тенев баир ул Васил Левски ул Княз Борис I
...... електронната си поща те могат лично да получават информация за планираните спирания. Друг начин е да се възползват от безплатната услуга за известяване чрез СМС.
бул Ботевградско шосе ул 55 ул 6 и ул 8 При
...... електронната си поща те могат лично да получават информация за планираните спирания. Друг начин е да се възползват от безплатната услуга за известяване чрез СМС.
Американците може да се наслаждават на по евтините луксозни стоки в
...... Америка през първото полугодие. Още по-висок растеж в Европа бе предизвикан частично от американски туристи, възползващи се от силния долар спрямо еврото и британския паунд.
Опасността от разпространението на пандемията COVID 19 промени ежедневието на децата
...... непоносима за децата, а сърцето на всяко дете се покорява с обич. Когато тя е двойна, детето е наистина щастливо, казват още от ДАЗД.
Учени откриха микроби живеещи при 89 градуса Целзий в силно
...... кацна роувърът "Спирит".--> Макар и Марс сега да е пустинен, много данни насочват, че вероятно там е имало големи водни басейни преди три-четири милиарда години.
Снимка БулфотоУчени откриха микроби живеещи при 89 градуса Целзий в
...... където кацна роувърът "Спирит". Макар и Марс сега да е пустинен, много данни насочват, че вероятно там е имало големи водни басейни преди три-четири милиарда години.
Учени откриха микроби живеещи при 89 градуса по Целзий в
...... кацна роувърът "Спирит". Макар и Марс сега да е пустинен, много данни насочват, че вероятно там е имало големи водни басейни преди три-четири милиарда години.
Учени откриха микроби живеещи при 89 градуса по Целзий в
...... кацна роувърът "Спирит".Макар и Марс сега да е пустинен, много данни насочват, че вероятно там е имало големи водни басейни преди три-четири милиарда години. /БТА